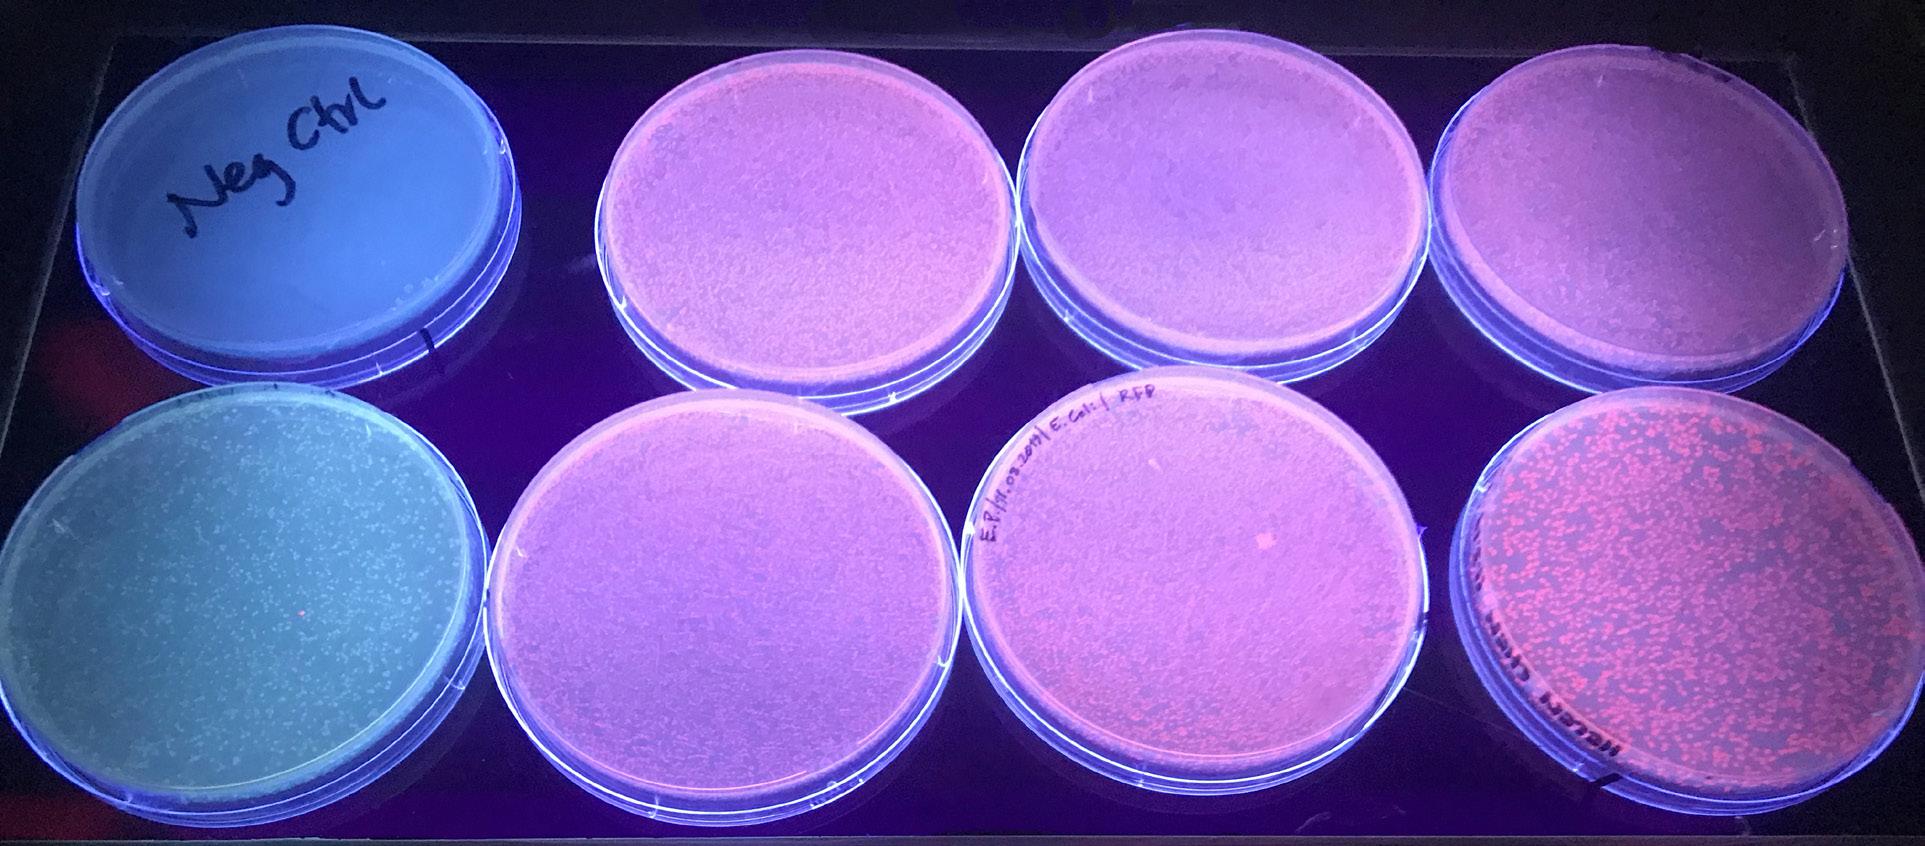
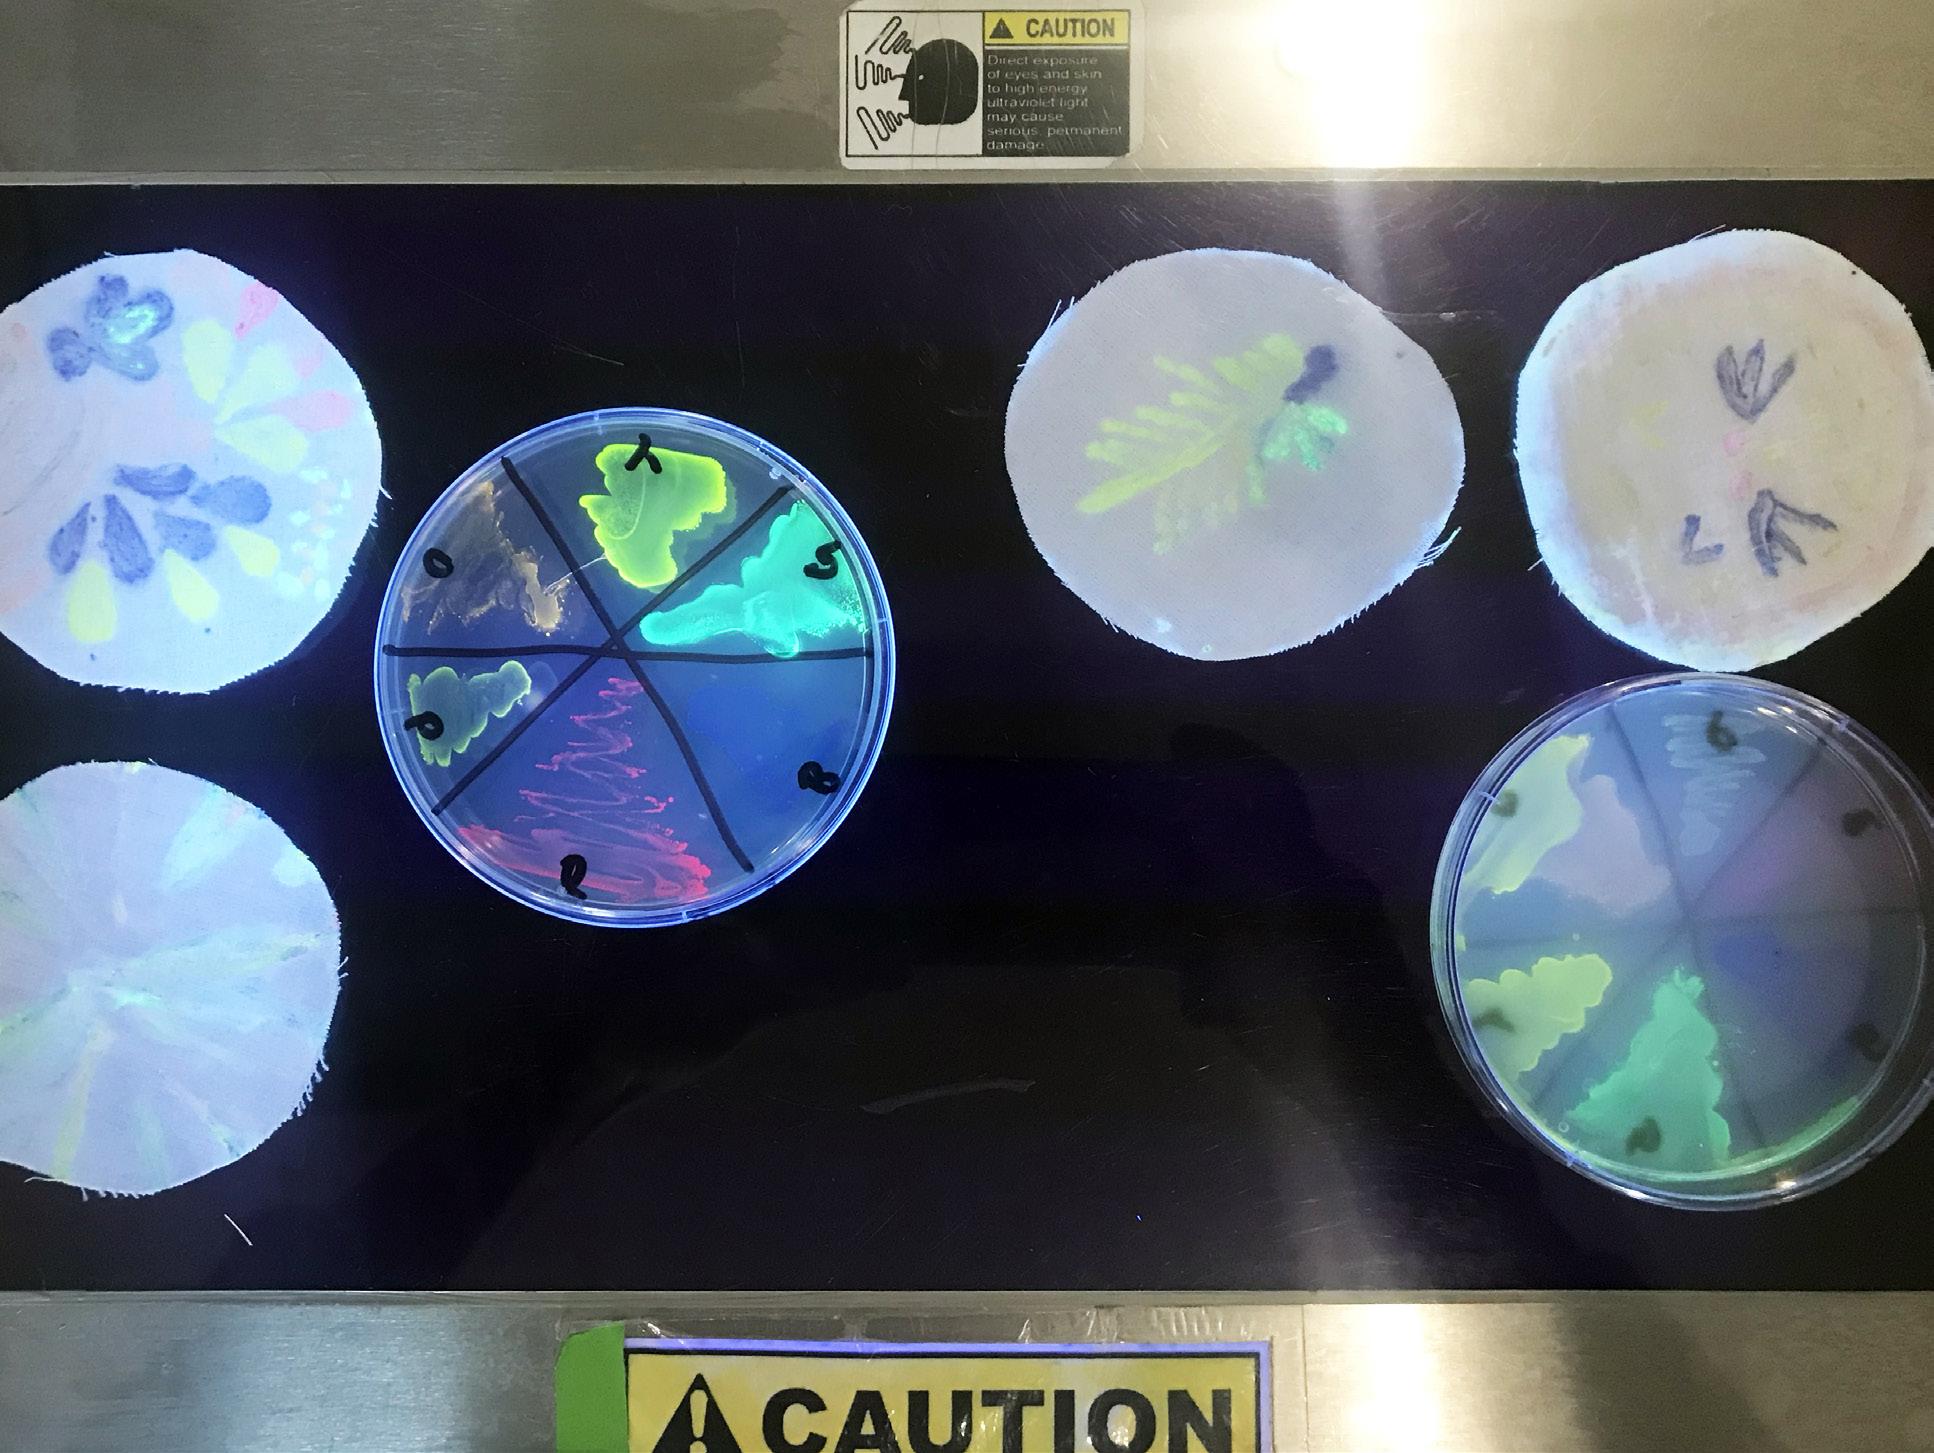

Fruiting Bodies Fungal Futures for Collaborative Survival
 By Helen Yin Chen
By Helen Yin Chen
Fruiting Bodies: Fungal Futures for Collaborative Survival


This publication accompanies the MFA thesis of Helen Chen, conducted at the School of Visual Arts in New York City.
©2020 All Rights Reserved by Helen Yin Chen
Author
Helen Chen
Book Editor
Jamie McGhee
Book Designer
Helen Chen
Department Chair
Allan Chochinov
Thesis Advisor
Jennifer Rittner

This book is dedicated to my grandmother, the woman who taught me to be bold and curious, to always look for the unseen connections in life.

"FUNGI SHOW US THAT THE PREDOMINANT MECHANISM OF NATURE IS ONE OF COLLABORATION AND SYMBIOSIS, NOT COMPETITION.”
6 FRUITING BODIES
— Sue Van Hook, Mycologist
Abstract
Fungi as Product, Process, and Provocation for a Multispecies Future
Fruiting Bodies: Fungal Futures for Collaborative Survival explores how new material ecologies and interspecies consciousness can create a paradigm shift in current industrial modes of production and consumption. In order to address the urgency of landfill and chemical waste streams around the world, this thesis begins with the experimentation of prototyping biomaterials ranging from bacterial cellulose to algae-based bioplastics and mycelium. Mushrooms ultimately become the central focus through framing the species as product, process, and provocation. Mushrooms and their mycelial root networks are both metaphors for a collaborative interspecies future and a feasible solution to help remediate and heal the planet’s ecological damages. Going beyond traditional formulas of design methods, the designs in this thesis operate within the framework of form, function, and care to design for relational innovations that decenter anthropocentric perspectives, aim for ecological justice, and embed the principle of invested care for other species.

7 FRUITING BODIES ABSTRACT
1 2 3 4 5 6 7 8
TABLE OF CONTENTS
Key Terminology An-Manifesto The Landscape Literature Review Design Principles Research Methods Key Projects Concluding Thoughts 13 16 19 22 33 37 60 98
Preface Foraging for Maronen
— Anna Tsing, The Mushroom at the End of the World
The first time I went foraging for mushrooms was on a chilly Sunday morning in late October 2016 in the woods of Birkenwerder. My friend Vincci and I rode the S-Bahn to the outskirts of Berlin with baskets and a field guide to wild mushrooms, eagerly anticipating the adventure ahead. Having foraged for mushrooms before in these very woods, Vincci acted as my guide as we entered. “Looking for mushrooms is like a game of hide and seek. You have to keep your eyes on the ground as you walk and look for cap-like structures emerging from piles of fallen leaves and branches,” she instructed me. We walked around slowly and marveling at worlds and assemblages that had always been more acquainted with my footsteps than my gaze. I could feel the sunshine piercing through the trees and hitting my hands and back with warmth, as we roamed for two hours in wintry weather.
Foraging for mushrooms demands the art of patience and one’s full attention. We came across a variety of mushrooms that I quickly and rashly identified incorrectly, while Vincci insisted that we carefully examine the caps, their undersides, and the stems. “This looks like the edible species you picked out from the book, but if you look at the gill structure, it’s actually more like this poisonous species,” she said. The search was fruitless for the most part, but I was astounded at how little I knew about life in these adjacent natural worlds. The more we began to notice and pick things apart on this journey, the more complex, intricate, and interconnected these forest assemblages seemed.
10 FRUITING BODIES PREFACE
1 Anna L. Tsing, The Mushroom at the End of the World: On the Possibility of Life in Capitalist Ruins. Princeton (Princeton University Press 2015) 33
“To walk attentively through a forest, even a damaged one, is to be caught by the abundance of life: ancient and new; underfoot and reaching into the light.” 1
“Helen—come here! I think I found patches of maronen mushrooms in these fields!” Vincci yelled to me from ahead. After two hours of walking and searching, we came upon a field that had small patches of maronen mushrooms (bay boletes) spread throughout. I learned from Vincci that these are very rare and delicious edible mushrooms, with a porous gill structure that bruises a teal color when you apply pressure. We carefully picked a few large maronens and placed them in our baskets, making sure to only take less than a third of what populated the field. On our way back, an elderly German woman spotted the mushrooms in our baskets and asked us where we found them. It turned out she is an avid mushroom forager who had been roaming the same woods for three hours without finding any edible mushrooms. It turned out that what Vincci and I had in common with this woman was that
our curiosity about and our search for mushrooms led us to experience worlds that unfolded before us in the quiet woods of Birkenwerder.
This mushroom foraging experience lies at the intersection of how I became a designer and researcher interested in ecology—the study of systems and networks based on the relations between different species, organisms, objects, and structures in a physical environment. During my time living in Berlin, my professional practice was in the world of food. I had a food studio called Lady Marmalade, where I made jams to sell at farmers’ markets and partnered with other food establishments to host pop-up dinner events. With easy access to fresh ingredients such as mint, pine, and berries in the forests surrounding Berlin, I began regularly going on foraging trips. It was through foraging that I became
 Birkenwerder, Brandenburg, Germany, October 2016
Birkenwerder, Brandenburg, Germany, October 2016
aware of the biological conditions of production; that is, where certain food resources originate from, their surrounding environments, and the interconnected systems of life. As someone who spent the first two decades of their life in two of the most densely populated and urbanized metropolises in the world, Shanghai and New York, my time roaming in these forests began breaking down the human-nature dichotomy that I internalized through my upbringing.
Becoming an Ecological Designer
Working with food shifted my focus as an artist and designer into systems thinking, specifically around exploring the impact that the current conditions of industrial production of products and infrastructure has on our planetary ecosystem. This shifted from a human-centered perspective and towards a multispecies narrative. I went from making and selling food to designing speculative future food systems and smart cities. I developed a materialist philosophy through all of this work, that is, all systems can be synthesized through their material inputs and outputs. This thesis is an exploration of new material practices that respond to the ecological damages caused by current conditions of industrial production. These new material practices establish new tenets of design that can create paradigm shifts towards a multispecies future that address environmental justice. In addition to presenting a suite of designed products, this thesis argues that design is inevitably tied to social ideologies; therefore, in order to use design to catalyze a paradigm shift, we must unfold the layers of the design process and establish new methods, frameworks, and principles.

12 FRUITING BODIES PREFACE
Maronen mushroom and a field guide to mushrooms written in German
KEY TERMINOLOGY

Biome
Biological community formed around a distinct physical climate and/or set of environmental conditions.
Commensalism
Biological interaction between two biological organisms where neither benefit nor are harmed.
Conditions of Production
Extension of the Marxist notion that when evaluating industrial/capitalist production, one must consider the labor (human and nonhuman) and environmental infrastructure involved.
Ecology
Study of systems and networks based on the relations between different species in an abiotic landscape.
Ecological Justice
Fair treatment and inclusion of all living organisms in the development and implementation of environmental laws, regulations, and policies.
Ecosystem
A community of living organisms within an environment.
Interspecies Consciousness
Acknowledgement that we live in complex ecosystems involving both human and nonhuman life.
14 FRUITING BODIES KEY TERMINOLOGY
Material Ecology
Network of relationships between artificially constructed/man-made entities, e.g. clothing, furniture, buildings.
Materialism
Philosophical argument that material processes and material outputs are simultaneously born from and form the sociocultural and political interrelations between humans and nonhumans.
Metabolism
Process of converting matter/energy inputs into a different matter/energy output; this concept can be applied to biological, mechanical, and digital systems.
Multispecies
Posthuman concept that different species living amongst each other are inextricably interconnected and interdependent, thus subverting the human-nature dichotomy.
Mutualism
Biological interaction between two biological organisms where both organisms benefit.
Resource
Biotic and abiotic elements extracted from their original habitats and converted into material for human-centered production and consumption.
15 FRUITING BODIES KEY TERMINOLOGY
AN-MANIFESTO A MULTISPECIES COVENANT

An-Manifesto is a reference to Gordon Matta Clark’s practice of anarchitecture—an art practice of cutting holes out of buildings as a visual statement that questions the oppressive state of architecture and real estate development fueled by capitalism.
Combining the ideas behind anarchitecture with Donna Haraway’s Cyborg Manifesto, this Multispecies Covenant establishes a set of principles that subverts the current conditions of industrialization.
02 We Have Never Been Alone
When asking questions around stakeholders and participants, we must extend inclusion beyond humans and consider the other species within a set ecosystem, and establish systems of multispecies cultivation.
The human identity is relational, fluid, and the sum of internal and external elements and organisms, ranging from the microbes in our guts to the trees and birds that contribute to the formation of the conditions of our survival.2
We must acknowledge the contribution of these companion species and establish mutualistic and commensalistic relationships in place of current extractive practices.
2 Zöe Schlanger, “Our Microbes, Ourselves,” Method Quarterly
01 Questions, Creatures, Cultivation 17 FRUITING BODIES AN-MANIFESTO
Waste
in Nature
Waste is a human-centered concept, where biotic and abiotic elements are deemed of no use value and abandoned. Biological processes, however, operate in a closed-loop system where one organism’s output is a source of input for another. We must go from a utility-waste paradigm to a circular paradigm and embed ourselves, humans, as a part of the larger ecosystems, rather than separate.
04 Uncover and Embrace Ancestral Intelligence
The notion of a covenant of interspecies care between human and land is not a new concept. Indigenous land-use and agricultural practices were founded upon tenets of multispecies respect and care. According to Rowen White, a seed steward from the Mohawk community, human flourishing is dependent on ecologicalflourishing, through a covenant between human and land.
The legacies of colonialism and capitalism sought to erase such practices and have in turn inflicted environmental injustice against indigenous, racially marginalized, and socioeconomically disadvantaged communities. A multispecies future is the key to reclaiming ecological justice, and in order to achieve this, we must uncover and embrace ancestral intelligence.

03
There Is No 18 FRUITING BODIES AN-MANIFESTO
THE LANDSCAPE

CORE USERS


20 FRUITING BODIES THE LANDSCAPE
LITERATURE REVIEW

1. Why Fungi Matters
“Why has the world-building of fungi received so little appreciation? Partly, this is because people can’t venture underground to see the amazing architecture of the underground city.”
— Anna Tsing
In his book, Mycelium
Running: How Mushrooms Can Help Save the World, Paul Stamets describes the world of soil beneath our feet as a carnival of activity “with mycelium constantly running through dancing bacteria and swimming protozoa with nematodes racing like whales through a microscopic sea of life.”3 Mycelium is the vegetative part, the root system of fungus, that produces fruiting bodies of mushrooms. Known as “nature’s internet,” it is the most vast network under soil, consisting of branch-like threads that extend for miles, connecting different live forms. Mushrooms and mycelial networks help forests grow in daunting places, protecting neighborhing species from parasites, decomposing surrounding toxins, and sending other species nutrients. The connective qualities of mycelium provide us with great insight into how we can live collaboratively within our ecosystem in an interspecies context, through their willingness to emerge in blasted landscapes and see industrial damage as an opportunity for repair.
Beginning in the mid-eighties, mycology, the study of fungi, has experienced a growing interest in the global North4 among interdisciplinary sectors looking to the fungal kingdom as a solution for environmental remediation and medicinal and nutritional needs, ranging from materials innovation, toxic chemical biosorption, and carbon sequestration, to immunological repair and mushrooms as a source for food sovereignty. In this way, the fungal kingdom serves as a biological entity and process that addresses a multiplicity of existing ecological problems. Simultaneously, current scientific understanding only unveils a small percentage of the intricacies and diversity of fungal lives. Thus, this thesis addresses the existing body of fungal knowledge and discoveries in the context of applied mycology, the exploration of fungi as a product, process, and provocation through the practice of design.
3 Paul Stamets, Mycelium Running: How Mushrooms Can Help Save the World (Crown Publishing Group, 2005) 35
22 FRUITING BODIES LITERATURE REVIEW
4 I emphasize the resurgent interest in mycology in the global North because the practice of working with fungal species for environmental repair has been ongoing in non-Western cultures for centuries prior. While clinical applications of fungi, such as the invention of Penicillin occurred in the early 1900s, the interest in mycoremediation and myco-materials has only emerged in the last few decades.
Mushroom as Product

Through the things humans deem no longer of use value, Anna Tsing argues that current modes of capitalist, industrial production places us in “a dream of alienation that inspires landscape modification in which only one stand-alone asset matters and everything else becomes weeds or waste,”5 leading to ruins and spaces of abandonment. Fungi act as regenerators and recyclers that stitch worlds together in ways that ask us to reconsider our relationship to waste and decomposition.
According to Harvard mycologist Donald H. Pfister, fungal species, especially mushrooms, are able to adapt and grow on different substrate compositions through environmental conditioning, dependent upon the fundamental measurements of
structural composition, pH, moisture, nitrogen, and oxygen. Scientific discoveries have shown their ability to thrive in landscapes that have been chemically destroyed by human industrial activities. Using potent cocktails of enzymes and acids, fungi can break down some of the most stubborn substances on the planet, from agricultural waste to crude oil, PU plastics, and TNT.6
There have been a number of ongoing endeavors that utilize mycelium’s ability to convert waste into nutrients for its own growth as a platform to establish new food and material systems.
5 Tsing, 4.
6 Merlin Sheldrake, Entangled Life: How Fungi Make Our Worlds, Change Our Minds, and Shape Our Futures (Random House, 2020) 10.
Diagram of Applied Mycology in design

 Mushroom entrepreneurs in Zimbabwe Image credit: Future of Hope Foundation
Mushroom entrepreneurs in Zimbabwe Image credit: Future of Hope Foundation
24 FRUITING BODIES LITERATURE REVIEW
Mycelium packaging grown from food waste Image credit: Ecovative Design
The Future of Hope Foundation, founded by Zimbabwean entrepreneur Chido Govera, is an organization centered around mushroom farming education to combat food and income insecurity in substance communities. They help facilitate research and implementation around mushrooms as an entrepreneurial initiative. Govera discovered that mushrooms can grow quickly and abundantly on agricultural waste on a small piece of land, making it a viable source for food and financial income (selling mushrooms as a product), while maintaining the ecological integrity of the area. In addition to being a food source, fungal mycelium is a dense network with congealing properties that can convert waste matter into new materials of varying qualities that can serve as a replacement for plastics. Ecovative Design is a materials company at the forefront of myco-material innovation, growing mycelium products, such as packaging, building insulation, and replacement leathers, from agricultural waste. Mycelium-based materials not only counter the current state of plastic pollution, but also help sequester carbon.
MUSHROOM AS PROCESS
More than ninety percent of plants in the world depend on mycorrhizal fungi for its survival. Mycorrhiza is the mutual symbiotic relationship between plant and fungi species, usually occurring through a network of nutrients and information sharing between their root systems. According to Merlin Sheldrake, “the entangled relationship between plants and fungi are the key to understanding how ecosystems work.”7 That is, the collaboration between the two biological kingdoms forms a foundational source of life for all organisms through photosynthetic and soil-nurturing activities. Harnessing this partnership, mycoremediation has become a critical process in environmental remediation efforts to restore damaged ecologies and biodiversity. Several research studies have shown the power of fungi as a fast, safe, low-maintenance, and costeffective biological tool for cleaning up the environment, through the removal of metals and pollutants from soils. Endeavors led by Paul Stamets and the Amazon Mycorenewal Project have proved the effectiveness of mushrooms adjusting to new industrial landscapes and growing life from pollutants and simultaneously reintroducing other biological life into these barren areas (see Projects section for more elaboration on mycoremediation and fungi as process).
25 FRUITING BODIES LITERATURE REVIEW
“As a species, humans are adept at inventing toxins yet equally inept at eliminating them from our environment.”
— Paul Stamets
7 Sheldrake, 18.
Fungi as Provocation

How can we use fungi to establish new relational modalities between humans, nonhuman species, and their environments in order to create a cultural-material paradigm shift? In addition to providing feasible methods of ecological regeneration, looking to fungal also guides us to the possibilities of coexistence within environmental disturbance through new relationships. Its ability to compose life from decomposition subverts our current modes of production, from linear to circular and collaborative models.
Fungi Mutarium is a speculative
design project by Livin Studio in collaboration with Utrecht University, that looks at plastic waste as a potential food source for humans. Building off of the research that pleurotus ostreatus (oyster mushrooms) is able to break down PU plastics as a substrate, this project culminates in a product that is a chamber for harvesting plastic waste in an agar and mushroom spore solution into a food product. Unlike the mushrooms grown as a food source by The Future of Hope Foundation, this project explores how plastic waste, after being broken down by mycelium, can be a food source.

While the framing of fungi as product, process, and provocation is one of the main design principles in this thesis, the following section of the literature review will unpack the relationship between design and the epistemological and ontological forces that uphold, justify, and perpetuate ecological destruction. Anna Tsing argues that “capitalism entangles us with ideas of progress and with the spread of
techniques of alienation that turn humans and other beings into resources.”8 Thus, to truly move away from current conditions of industrial production, we must question the structural forces of colonialism, capitalism, and geopolitics that have led to the arbitrary value of the human.
8 Tsing, 10.
Fungal Mutarium Image credit: Livin Studio
26 FRUITING BODIES LITERATURE REVIEW
Mycelium-agar-plastic waste as food Image credit: Livin Studio
Mini Glossary 1
Fungi
Kingdom in the biological taxonomic system that includes yeasts, molds, and mushrooms.
Mycelium
Vegetative (root system) of fungus that consists of branch-like threads called hyphae, also known as “nature’s internet”.
Mycorrhiza
Mutual symbiotic relationship between plant and fungi species, usually occurring through a system of nutrient and information sharing through root systems.
Mycoremediation
Process of growing mushrooms to remove soil and plant toxins via the organism’s ability to decompose toxic matter and replenish needed nutrients using its root system as a nurturing and protective infrastructure under soil.
Substrate
Compound/material from which an organism obtains its nutrients for growth and life.
27 FRUITING BODIES LITERATURE REVIEW
2. From Human-Centered Systems Towards Multispecies Futures
Posthuman Politics
Stakeholders, groups without whose support an endeavor would cease to exist, are critical to user-centered design practices in understanding who we are designing for and how we are addressing their needs. LinYee Yuan argues that the notion of the stakeholder is inextricably linked to the politicization of rights of actors within any system/ network.9 An issue with current political systems is that they are founded on terms that are exclusively human, even if they exist in knowledge—making and material practices that involve other species. Thus, we must extend the notion of the political actor to include nonhuman species and acknowledge that “the material relations between different living species, human and nonhuman are related to ecological and political outcomes.” 10 Interspecies politics reveal an opportunity to design for inclusivity through relationality versus static hierarchical structures.
In her essay, “Nonhuman Labor and the Making of Resources,” Anna Krzywoszynska talks about soil maintenance as a collaborative effort between soil-based microorganisms and human activities, that can be examined and reframed through different perspectives on the politics of labor. In this case, labor is defined as the physical and intellectual activity performed by biotic organisms to achieve human resource and capital accumulation.
9 LinYee Yuan, Personal Interview (10 April 2020).
10 Rafi Youatt, “Interspecies,” The Oxford Handbook of Environmental Political Theory (Oxford University Press, 2016) 216.
The Politics of Labor: From "Working" to "Working With"
28 FRUITING BODIES LITERATURE REVIEW
“What could ‘individual selection’ mean if all organisms were chimerics, and there were no real monogenic individuals?”
—Scott F. Gilbert, “A Symbiotic Way of Life”
Soil fertility, Krzywoszynska argues, is a relational accomplishment between human and nonhuman processes, in which the current state is framed as the activity of soil-based organisms existing under human management.11 However, the notion that capital and resource production are the result of partnerships between humans and nonhumans prompts us to “ask about multiple versions of the human articulated in and with different assemblages of the non-human, including animal, natural, material, technological.” 12 Thus, in conversation with the earlier point around extending stakeholder rights to nonhuman species, we must shift our current perspective on “working nature” to “working with nature,” transforming the conditions of capital accumulation from an extractive labor-based model to a collaborative interspecies model.
Pier 35 EcoPark is a project collaboration between The Living and Natalie Jeremijenko that uses a hybrid of biological and digital interfaces to rescript human relationships to their environments. The project takes visual and user experience cues from personalized health technologies and creates a platform to include both human and nonhuman participants. Specifically, the project looks to leverage and regenerate the existing biological infrastructure of New York’s harbors to establish resilience against natural disasters. The project creates new mussel habitats in the harbor and monitors their health levels through a series of biosensors. Human users receive notifications of any environmental and behavior changes of the mussels in the context of whether they are flourishing in their habitat. This project links human health with mussel health through highlighting their interconnected relationship within the ecosystem, necessitating the care of mussel habitats as critical to human flourishing.

 11 Anna, Krzywoszynska “Nonhuman Labor and the Making of Resources: Making Soils a Resource through Microbial Labor,” Environmental Humanities (vol 12, issue 1, May 2020) 236.
12 Rafi Youatt, “Anthropocentrism and the Politics of the Living,” Reflections on the Posthuman in International Relations (Bristol, E-International Relations, 2017) 40.
Interspecies communication app Image credit: The Living
11 Anna, Krzywoszynska “Nonhuman Labor and the Making of Resources: Making Soils a Resource through Microbial Labor,” Environmental Humanities (vol 12, issue 1, May 2020) 236.
12 Rafi Youatt, “Anthropocentrism and the Politics of the Living,” Reflections on the Posthuman in International Relations (Bristol, E-International Relations, 2017) 40.
Interspecies communication app Image credit: The Living
29 FRUITING BODIES LITERATURE REVIEW
Mussel habitats with biosensors Image credit: The Living
Similarly, the Microbial Home is a speculative project by Philips that looks to a possible future where the metabolic activity in the built environment is powered by biological processes in place of mechanical ones. In this scenario, the home is a closed loop system where systems of input and output for heat, water, food, and energy production are

a combination of microbial, fungal, and bee-based metabolic activities. The decomposition and/or byproduct of one biological entity becomes a source of nutrition and sustenance for another. Ultimately, human subsistence in this system is reliant on the nurture and care of companion organisms.
 Microbial Home Diagram Image credit: Cedric Bernard
Microbial Home Diagram Image credit: Cedric Bernard
30 FRUITING BODIES LITERATURE REVIEW
Microbial Home Installation Image credit: Designboom
Fungal Futures for Collaborative Survival
Within this area of inquiry, the network cohabitation between fungi and other species in an environment provides a framework for how we can transform from human-centered systems towards multispecies inclusivity through the concept of involution—the process over time in which organisms invent new ways of living alongside each other symbiotically. This thesis explores how
Mini Glossary 2 Biodiversity
to design from new relational modalities of interspecies relationships inspired by fungal principles of symbiosis, specifically in the context of materials production: How do we shift from practices of extraction to the acknowledgement of humans as co-producers and cohabitors with other organisms? That is, can the conditions of material production shift from a source of ecological damage to a form of stewardship?
Degree of variation in species types within an ecosystem.
Interspecies Politics
Rights and agency that nonhuman species have in human-centered systems.
Involution
Process by which organisms invent new ways of living alongside one another in an ecosystem.
Sixth Mass Extinction
Ongoing extinction of a multitude of species as a result of human activity.
31 FRUITING BODIES LITERATURE REVIEW
DESIGN
PRINCIPLES

1. Systems Design
“To design is to devise courses of action aimed at changing existing situations into preferred ones.”
—Herbert
How might we use the levers of design to transform the conditions of production and consumption in our material culture, through encouraging interspecies consciousness?
As a systems designer, I propose a framework that decenters human-centered design, moving away from traditional stakeholder structures of people, process, and place to species, metabolisms, and biomes.
Framework for de-centering human-centered design

33 FRUITING BODIES DESIGN PRINCIPLES
Simon
2. Form, Function, and Care
Traditional design practices (industrial and graphic) are rooted in its connection to the advertising and marketing sectors. Design was used as a tool for productization and increased market consumption. Even with transition to design-thinking and human-centered design, the value of user research is often used to optimize the journey to consumption. I’m interested in how we can use the levers of design as agents of transformation, as toolkits for creating paradigm shifts and behavioral changes in our current industrial modes of production and consumption.
“If industrial design is about form and function, can postindustrial design be about form, function, and care?”
Can adding care as a new tenet of design shift us away from current practices of resource extraction and industrial production, and towards a more ecologically-conscious and posthuman paradigm? Extending beyond form and function, the act of care requires attention, provision, maintenance, and protection that moves linear models of production and consumption into collaborative ones.

34 FRUITING BODIES DESIGN PRINCIPLES
Paradigm Shift Systems Diagram
— LinYee Yuan, Mold Magazine
3. Scenario Planning for Co-creating Futures

Borrowing from a methodology I learned while working as a design strategist at Arup, my co-creation workshops implement the foresight practice of scenario planning—collectively designing scenarios that are hypothetical illustrations of plausible futures. While Arup uses this methodology as a competitive strategy for clients, I have translated the content to consider prompts and toolkits as a way to highlight the multiplicity of voices needed in designing futures.
4. Democratic
and Participatory Design
While many of the designs that come out of this thesis process have a speculative edge and are looks-like models, I aimed to have my designs shaped by co-creation and participatory feedback. In addition to user interviews and observation, it was important to embed myself within the communities and spaces that I designed for, both the technical and social aspects. In my projects, I utilize the principles of democratic design through the continuous evolution of a project from external influence and by allowing the work to be open-source and shared with communities.
35 FRUITING BODIES DESIGN PRINCIPLES
Image from Laboratory for Biological Futures Workshop
5. Using Open Source and Calm Technology Principles
Expanding on the previous principle of democratic design, my co-creation workshops (see Biological Futures Laboratory, Biomaterial Futures Co-creation, and IoM: Growing Mycelium Zoom Session) are centered around education and knowledge-sharing. I share my materials research, recipes, and processes in order to allow participants to expand on my explorations in their own ways and share them with a greater community (like Public Lab). I am interested in how design and systems can evolve through collective participation. In order to effectively and quickly establish these sharing platforms, I adapted the following principle of calm technology: using existing platforms and responding to existing user behaviors (i.e., using Slack to prototype and communicate rather than designing a new platform).

36 FRUITING BODIES DESIGN PRINCIPLES
Growing Mycelium Zoom Session
RESEARCH METHODS

Developing a Practice Through Field Research and Experimentation
Innoculating reishi spores into food waste substrates

Preparing cochineal and alum solution for fabric dye tests at Genspace

1. Speaking with Experts
Throughout the thesis process, I had the opportunity to consult nearly forty subject matter experts, ranging from microbiologists, educators, material scientists and mycologists, to environmental economists, designers, and community organizers. I was able to gain insights from multiple perspectives regarding my inquiry into the relationship between multispecies futures and new material ecologies. In addition to strengthening the technical backbone of my thesis research from science and engineering experts, I was able to learn the critical role that designers can play in helping shape the narrative and systems infrastructure within this area of inquiry. It was incredible to see the interconnection of stakeholders working in the emerging space of biodesign, and to witness the level of enthusiasm and passion. It was also very inspiring to see how different experts approached similar topics and that this field really demands a multiplicity of voices.
Overall, I ran across a common message from the experts I spoke with— humanity needs to undergo a major paradigm shift, and capitalism as the dominant system of production and living is no longer sustainable. At the same time, there is growing interest in and advocacy around bio-inspired design and systems. We are once again turning to existing systems that we have long forgotten, made subservient, and taken for granted. From the biologists, plant enthusiasts, and mycologists I spoke to, I learned that there is so much wisdom to be learned from how other organisms live and organize. Nature carries millenia of evolutionary experience that we have so much to learn from. Why don’t we design with what already exists rather than create destructive linear, one-time systems?
39 FRUITING BODIES RESEARCH METHODS
“How can we rethink the economy of goods and services through designing solutions that are neither products nor services, but processes of nature?”
—Manon Otto, Landscape Architect, Mandaworks
To fully commit to a process of reworlding, education is a critical component. From several of the subject matter experts, I learned that educating people about alternative systems and having their active input is a must for catalyzing change in how society operates. There is a lack of access to general scientific and empirical knowledge, and therefore designing with biology can seem daunting, strange, and undesirable. According to Carlo Quiñonez, in order for biodesign to become a mass practice, biology needs hardware, just like man-made machines. Open-source knowledge and practices can help facilitate collaboration and advancement through the inclusion of multiple perspectives. In order to do so, biology needs a common and shared operating system. Speaking with Bronwen Densmore of Public Lab provided a hopeful insight into organizations who are committed to promoting access and the democratic practices of citizen science. These practices allow for the growth of open source platforms that are used by everyday people for critical issues such as air pollution and measuring bioremediation.
In my conversations with entrepreneurs and commercial designers, such as Kristine Salviejo of Nike and Julia Marsh of Sway, I learned that from a market perspective, customer perception of a transition to value-based
ecological practices is very important. If demand determines the market and, therefore, how the conditions of production operate, both Salviejo and Marsh think that a primary responsibility for companies is to be a source of education for their consumers. Corporations and their consumers want to transition to more ecological lifestyles, but the process of transition seems costly, daunting, and abstract. How can designers play a role in this educational opportunity?
40 FRUITING BODIES RESEARCH METHODS
“Materials can play a role in uniting the metabolic rift caused by the separation of monetary value from ecological value through establishing new relationships.”
— John Thackara
2. Genspace, as a Community Member, Student, and Teacher
Volunteering at a Community Biolab
Genspace is a community-based biolab located in Sunset Park, Brooklyn. It was founded in 2012 by a group of biologists, journalists, and entrepreneurs who shared a passionfor providing access to scientific knowledge and practices to non-industry professionals. The lab’s mission is that science should be available to everyone, and that the multiplicity of voices and actors in the field would ultimately contribute to the field’s advancement. I was lucky enough to spend Fall 2019 volunteering and taking classes at the lab. I first found out about Genspace through a long Google search on how I could gain fundamental technical knowledge for my thesis. I come from a liberal arts background and have not been in a science class since freshman year of college. Nevertheless, I wanted a technical component to my thesis and knew that I would have to learn the basics of microbiology and materials science to approach this topic. As a community biolab open to anyone interested in expanding their scientific knowledge, I decided to sign up for a volunteer information meeting in October. The space and the staff proved to be welcoming and passionate about science, and I was able to meet other
volunteers who shared a similar eagerness to enter and learn about a new field, but who did not necessarily have the knowledge, background, and resources. It felt nice to enter into a new community.
My first volunteering experience was at the Harvest Festival in Brooklyn Bridge Park, where I worked in a booth with five other fellow volunteers to teach visitors (mostly families) about the basics of bacteria, DNA, and biomaterials. There was a section for bacteria coloring sheets, a section for examining bacteria culture from fruits in petri dishes, a DNA extraction station, and a biomaterials section. Interestingly, I learned a lot about these subjects myself as I presented the content to families. I learned that you can extract strawberry DNA at home, in your very own kitchen. It was also amazing to see how enthusiastic visitors who stopped by the booth were at the information presented.
41 FRUITING BODIES RESEARCH METHODS
Harvest Festival at Brooklyn Bridge Park, October 2019

Image credit: Genspace
Petri dishes harvesting apple cells

October 2019
Image credit: Genspace
42 FRUITING BODIES RESEARCH METHODS
Learning Biology and the Fundamentals of Setting Up Lab Experiments

I also took several courses that the lab offered: a two weekend-long biohacking bootcamp and a two-day workshop on dyeing with bacteria and cochineal. Both courses have been critical to the addition of technical knowledge and clarification for my thesis. During the biohacking bootcamp, I learned about the fundamentals of microbiology, how to use lab equipment, process my own DNA, and inject bacteria with genetically-modified fluorescent cultures. These hands-on experiences provided me with insights on how to combine scientific and design methodologies in my work—the steps to carrying out scientific research and experiments to test hypotheses and then integrate them into a user-centered solution.
Teaching at Genspace
After volunteering at Genspace and taking classes at Genspace in Fall 2019, I had the opportunity to co-teach a workshop on growing mycelium as a material. Experiencing materials development from the teaching side was a very new endeavor for me. From the questions that the participants asked and from the different applications of the material that they were curious about, I was able to learn more about how to approach my research. This teaching experience became an important reference for how I approached the initial design of the educational and instructional aspects of a later project, IoM (see Projects section of this book).
43 FRUITING BODIES RESEARCH METHODS
Cultivating lab-grown E coli. bacteria to express specific colors, Genspace Fall 2019


 Processing DNA cells from saliva sample Biohacking Bootcamp, Genspace Fall 2019
DNA sequence in agarose under UV light Biohacking Bootcamp, Genspace Fall 2019
Processing DNA cells from saliva sample Biohacking Bootcamp, Genspace Fall 2019
DNA sequence in agarose under UV light Biohacking Bootcamp, Genspace Fall 2019
44 FRUITING BODIES RESEARCH METHODS
Students preparing to grow mycelium with hemp substrate during a workshop I co-taught Growing with Mycelium workshop, Genspace February 2020
3. Biomaterials Experimentation
“In order for biological processes to become a frameworkfor design and gain greater adoption by the public, it needs an established infrastructure of practice like hardware and software.”

45 FRUITING BODIES RESEARCH METHODS
— Carlos Quiñonez, Thermofisher
Bacterial Cellulose Leather & Bioplastics

During the first semester of my thesis year, I experimented with fabricating biomaterials in both DIY and lab settings. I started this journey with fermenting kombucha and learning that the SCOBY bacteria can be dried into a material that feels like leather. I began creating structures to dry the bacteria cellulose and experimented with different color infusions, teas, and drying conditions. Through this journey, I fell in love with the sensuous properties of biomaterials. I also became more aware of the evaluation criteria for

materials. For example, bacterial cellulose is very hydrophobic and overdrying it can leave it to become very brittle.
My adventures with bacterial cellulose led me to work with agar, corn starch, and chitosan bioplastics, as well as natural dyes, ranging from naturally extracted materials to geneticallymodified bacteria. Working with biomaterials is incredibly sensorial and somewhat unpredictable. The handson experience of making materials from scratch allowed for a greater understanding of material properties, behaviors, and the sources of their extraction.
Dehydrating a thin layer of kombucha SCOBY to produce bacterial cellulose leather
46 FRUITING BODIES RESEARCH METHODS
Sample of bacterial cellulose leather I made
Scrapbook-style photo collection of making biomaterials at the studio, cataloguing them, exploring materiality through light, and coming up with product applications





47 FRUITING BODIES RESEARCH METHODS


Dyeing Fabric with GeneticallyModified Bacteria

Dyeing fabrics with geneticallymodified bacteria was my first experience with materials production at the intersection of bio-manufacturing and bio-sensing. The process of creating dye-emitting bacteria involved genetically-modifying lab-grown E. coli cells to express particular colors when interacting with specific environmental conditions.
This particular method is very effective at reducing the high-volume water requirements for current industrial dye processes and the toxic pollutants from dumping chemical dyes. At the same time, using genetically-modified bacteria as a process for production raises another ethical question in the field of synthetic biology: What are the consequences of manipulating living organisms as tools for industrial production?
50 FRUITING BODIES RESEARCH METHODS
Cotton fabrics dyed with genetically-modified, lab-grown E.coli cells Dyeing with Bacteria workshop, Genspace December 2019
Working with Fungi as Material, Process, and Biosensing: Developing a Collaborative Partnership with Mushrooms
I spent the second half of the thesis year focusing on learning about mushrooms as material and process. I was introduced to mycelium as material through my ongoing materials research, and became fascinated when I learned about its ability to grow and solidify structurally from things we consider waste. As I tried to grow mycelium through different conditions and formats (from Petri-dish inoculation, to agricultural waste substrate, to pantyhose), I discovered what it meant to be in a collaborative partnership with another organism. It felt like choreography between species in understanding the behavioral and relational impact of one another’s actions

and environmental needs. It was a feeding and nurturing process, where I had to consider the environmental conditions through which it thrived, through constant observation and care. I was embedded in curiosity, always questioning whether the spores I placed in different substrates would grow and how they would grow. The trial and errors became a feedback loop between myself and the mushrooms.
 Preparing to grow pleurotis ostreatus (osyter mushroom) in a coffee husk, grains, and plastic bag substrate
Preparing to grow pleurotis ostreatus (osyter mushroom) in a coffee husk, grains, and plastic bag substrate
51 FRUITING BODIES RESEARCH METHODS
Testing mycelium growth with a variety of substrate types: coffee husk, coffee ground waste, and used grains
Scrapbook-style photo collection of growing mycelium in different environments, with different substrates, and using different spore innoculation methods





52 FRUITING BODIES RESEARCH METHODS


 Turkeytail mushroom gills examined under a microscope
Plastic bag pieces and grain substrate for growing oyster mushrooms
Turkeytail mushroom gills examined under a microscope
Plastic bag pieces and grain substrate for growing oyster mushrooms
53 FRUITING BODIES RESEARCH METHODS
Propogating oyster mushroom spores from growing mushrooms on a agar petri dish
4. Biomaterials Co-creation Workshop
Area of Inquiry
How do we create spaces that allow for the democratization of scientific knowledge-making and the active inclusion of a multiplicity of voices around biomaterials innovation? Who are we designing for? How might we include these stakeholders in the design process?

Workshop Format
After working with biomaterials for a few months, I became interested in how other people would perceive them and how this new material vocabulary can be integrated into new modes of production and consumption. Thus, I held a biomaterial futures co-creation workshop with twelve participants and a three-part agenda. The workshop
consisted of exploring, sensing, making, and designing.
The workshop was set up with a sensing and making station in the middle, where I had a collection of biomaterials I had been exploring laid out and labeled, as well as a papermaking station. The intention for the sensing and making station was to get the participants involved and acquainted with the materials. What do they feel like? Smell like? Look like? Sound like? What might they taste like? I wanted the experience to be full-sensory immersive before the participants headed into the design portion of the workshop. After the sensing and paper-making activities, participants were put into four groups, and each group had a prompt to design for.
54 FRUITING BODIES RESEARCH METHODS
Co-creation workshop participant using natural play dough material to prototype designs Biomaterial Futures Co-creation Workshop, Fall 2019
EXPLORING MAKING
DESIGNING SENSING


A particpant examining various bacterial cellulose samples at the materials table


 Photo excerpts from co-creation workshop highlighting the different aspects of the three-part workshop
and filling out the Sensing Worksheet
Photo excerpts from co-creation workshop highlighting the different aspects of the three-part workshop
and filling out the Sensing Worksheet
55 FRUITING BODIES RESEARCH METHODS
Workshop Outcomes
The outcomes were incredibly inspirational, and it was amazing to see how enthusiastic everyone was. Some highlights from the designs include:
1. A flexible and nutrient-rich houseplant holder made of agar bioplastics.
2. A jacket that acts as an internal sauna for cold and wet weather, taking inspiration from stoma contraction in leaves.
3. A charcoal and bioplastic-based air filter that uses New York City scaffolding as the structure, and can make money from advertisements.
Key Insights
The key insights from the workshop were:
1. Utilizing the senses as a tool for exploration and communication: Getting the participants to interact with the materials physically—touch, smell, and hear—was a very powerful way to introduce them. Some participants would throw the material on the table to listen for differences in sound quality as a comparison for bounciness. Other participants were fascinated at how the materials felt on their skin compared to other surfaces.
2. Making is key to the design process:
The paper-making exercise was many of the participants’ favorite activity— it connected the material exploration portion with actual fabrication, which allowed people to sense and interact with materials on a deeper level.
3. Designers, makers, and artists are hungry for alternative modes of production and creation:
It was very eye-opening to witness that the participants were interested in taking what they learned during the workshop and thinking about ways of applying this new knowledge to their practice. The follow-up has been amazing—several participants have continued working with biomaterials, even at a professional level. This workshop proves that the dissemination and democratization of knowledge is essential for innovation, and we can only design for more inclusive, equitable, and safer worlds through the multiplicity of voices.
56 FRUITING BODIES RESEARCH METHODS
Participant share-outs of their design responses to the prompts they were given to work on in groups



57 FRUITING BODIES RESEARCH METHODS
5. Teien Living Jacket
LATTICED STRUCTURES FOAMS/SPONGES KNITTED FORMS
[Structural explorations of Teien jacket, based on agar bioplastic]

Area of Inquiry
What if the human body became the mobile ecosystem and topography on which other life grows? Can interspecies relationships be externalized as a garment? What kinds of relationships arise from this new assemblage?
Garment as a Microbiome
For this project, I am interested in both technical and social design components: an exploration of material futures and the imagined futures for ecological communities that can be manifested through this new medium.
Structurally, I experimented with creating agar bioplastic-based mesh and sponge structures inspired by grow walls in architecture and geo-textiles.
As for the social design aspect, the jacket becomes a site where different biomes intersect and create the potential for new spatial, trophic, and emotional relationships. I am exploring scenarios of interspecies reworlding through three main ideas: wellness and biophilia, mutualistic symbiosis, and crosspollination. Evolutionarily speaking, humans through their parasympathetic nervous systems innately long to be a part of nature. How can this be utilized for multilateral harmony, in which humans can act as agents of nurture for other life?
58 FRUITING BODIES RESEARCH METHODS
“Materials are really rich, because they are not yet an object, and therefore they have a space for possibilities and connection to larger systems. They have a legibility to their origins and ecosystem.”
— Julia Lohmann, Department of Seaweed, Aalto University

59 FRUITING BODIES RESEARCH METHODS
KEY PROJECTS

1. Biomimic-Me!
Multispecies Co-creation Toolkit for Urban Design
Rendering of Biomimic-Me! card set

Area of Inquiry
How can we design for multispecies futures that are not centered on humans?
Terms
Biomimicry: human-made design of materials, structures, and systems based (both symbolically and literally) on biological processes.
Project Type
Co-creation toolkit, workshop design, speculative design.
Core Users
Designers, urban strategists, teachers, students, nonhuman species.
61 FRUITING BODIES KEY PROJECTS
Introducing Biomimic-Me!
Biomimic-Me! is a toolkit for designing urban futures from a multispecies point of view. It is a set of cards with information about biological features and processes found in nature and is divided into three main categories: communication, technology, and systems. Each card also has a subcategory, such as sharing economies, that connects it back to a familiar human-generated concept. The intent for these cards is to be used as reference material to help participants respond to an area of inquiry or a problem statement with ideas that extend beyond systems already familiar to humans. In this way, Biomimic-Me! is a toolkit for biomimicry in the co-creative design process, both engaging the participants to conceptually and literally incorporate nonhuman biological processes.
The inspiration for this project comes from a combination of my interest in co-creation as a tool for democratic design and pedagogy, my conversations with biodesign and interaction design experts AnnMarieThomas 14 and Dan Lockton, and my previous work in designing futuring workshops for smart cities at Arup. I saw an opportunity to design a toolkit that can be used in a workshop format that would allow for the integration of a multispecies paradigm shift from an established framework of people, process, and place to species, metabolisms, and biomes with urban design—an ecosystem founded on the entanglement between humancentered design and a coexistence among nonhuman species.
14 AnnMarie Thomas and Mark Breitenbeg, “Engineering for Non-engineers: Learning from ‘Nature’s Designs’,” American Society for Engineering Education (2007)
62 FRUITING BODIES KEY PROJECTS
“We just don’t realise the value we could have in using design methods to understand the world, rather than just attempt to ‘fix’ one particular framing of it.”
— Dan Lockton, Carnegie Mellon University

63 FRUITING BODIES KEY PROJECTS
Rendering 2 of Biomimic-Me! card set
Share-out of each group’s favorite ideas and synthesizing common themes

 Participants brainstorming with Biomimic-Me! cards
Participants brainstorming with Biomimic-Me! cards
64 FRUITING BODIES KEY PROJECTS
Co-creation Workshop

In order to test and iterate these cards, I held a co-creation workshop called Laboratory for Biological Futures with some fellow Products of Design classmates. Six people were paired into three groups to respond to the question of: how can we design how we eat, where we eat, and what we eat in Chelsea, Manhattan? Each group was assigned an area of focus within designing new food futures in Chelsea: business models, materials & spaces, and resources & distribution. I divided the hour-long workshop into four phases: familiarizing with the Biomimic-Me! cards, rapid ideation, visualizing a chosen design, and a share-out at the end.
Integrating Participant Feedback
At the end of the workshop, I held a ten-minute reflection session where I asked the participants to provide me feedback on what they thought of the workshop structure and the Biomimic-me! cards. The common feedback that I received was that the cards contained a lot of interesting and new information that the participants wished they had more time to absorb, and that they wished there was more direction and guidance on how to use these cards in a brainstorming context.
 Physical protoype of Biomimic-Me! cards used in the workshop
Physical protoype of Biomimic-Me! cards used in the workshop
65 FRUITING BODIES KEY PROJECTS
Resources & distribution team ideating
2. Internet of Mycelium (IoM)

Enabling Ecological Justice through Mycoremediation
Area of Inquiry
How can we use the decomposition properties of fungi to provide communities with affordable and resilient solutions to maintaining local soil health?
Terms
Ecological succession: the gradual process by which ecosystems change over time due to natural disasters, climate change, interspecies interactions, and human-led industrial activities.
Soil biota: the flora and fauna of a soil ecosystem, i.e., all the organisms and microorganisms that live from and contribute to soil heath.
Project Type
3D product design, service design, systems design, digital interaction design
Excerpt from IoM website
66 FRUITING BODIES KEY PROJECTS
Core Users and Stakeholders
Urban gardening and food-growing communities, small-scale farming communities, soil-remediating mushroom species, soil-based organisms.

Introducing IoM
Internet of Mycelium (IoM) is a company that provides mycoremediation and soil testing services to the urban gardening communities to tackle the growing problem of deadly soil contamination 15 in cities around the world. The company currently works with small-scale farmers, urban gardeners, and landscapers to remediate and regenerate urban soil and industrial brownfield lands throughout the United States. IoM combines the capabilities of biotechnology, data-driven science, and ancestral land-care techniques to provide customized and affordable solutions for clients. It does so through a three-part service structure: soil-testing & mycoremediation kits, Myco Journal App, and the Soil Lab platform for knowledge-sharing.
This is a project about human collaboration with mushrooms to regenerate our urban soil ecosystem in a holistic and affordable approach
through the principles of nurture and care. The following sections will address how IoM responds to the current technological and user-centered gaps in the mycoremediation market, a critique of current environmental remediation practices in the context of labor politics, and the next steps for the project.
15 “Polluting Our Soils is Polluting Our Future,” Food and Agriculture Organization of the United Nations (5 Feb 2018).
67 FRUITING BODIES KEY PROJECTS
Person de-rooting soil Image credit: United Nations
IOM’S CORE VALUES
1. Providing holistic and long-term health for soil.
2. Providing guidance and access to citizen science through knowledge-sharing an opensourced information.

3. Embedding the principle of invested care in for people engaging in mycoremediation.
4. Enabling community-based environmental resilience.
5. Maintaining practices that consider the soil biota as a core stakeholder in the mycoremediaition process.
68 FRUITING BODIES KEY PROJECTS
Research on the Current Landscape of Environmental Remediation
The environmental remediation and clean-up services market in the U.S. is projected to value at 18.8 billion dollars in 2020, but these services are often very expensive and catered towards large agricultural and land management companies. While these industrial and chemical-based technologies are very effective at quickly removing pollutants in soil, they also compromise soil quality and health through forcefully interfering with the soil microbiome. At the same time, there is an increasing need for affordable and accessible solutions to the growing problem of soil contamination in cities and communities near brownfield lands.

In the past two decades, there have been significantly high toxicity levels in urban soil plots due to industrial waste pollution, water source pollution,
and the spread of chemical materials as a result of temporal accumulation and natural disasters. In the case of New York City, the Brooklyn College Soil Research Lab and New York City Urban Soil Institute evaluated 126 garden systems throughout the city pollution and ecological risk, and discovered soil lead levels significantly above the acceptable levels of 400ppm in sections of northern Brooklyn, northern Manhattan, and southern Bronx.16 Heavy metals, particularly lead, in soils are major hurdles for urban agriculture and gardening activities can cause public health risks. Through the food we eat, the water we drink, and the air we breathe, soil contamination leads to long-term neurological, immunological, and epidermal diseases.
Image adapted from “The Mycoremediation Handbook” 69 FRUITING BODIES KEY PROJECTS
16Anna Paltseva and Zhongqi Cheng, “Application of GIS to Characterize Garden Soil Contamination in New York City,” Global Symposium on Soil Pollution (2018)
Image credit: Tulane University

Image credit: Brooklyn College

Soil Research Lab
Environmentalist Leila Darwish argues that ecological healing in urban landscapes requires both government support and the establishment of methods that are accessible and empowering for the affected communities. In order to reclaim ecological resilience within communities, it is important to embed the skills and infrastructure for direct action.17 Echoing the environmental justice framework discussed earlier in this book, the infrastructure for local ecological justice must pair systemic policy with the toolkits that enable affected communities to gain access to the information and processes for the materialization of resilient solutions. Furthermore, extending this into a consideration of the multispecies covenant, the infrastructure of soil
consists of a complex and entangled network of stakeholders that have an impact on one another through their metabolic activity and ultimately through the interspecies food chain and ecosystem at large. Thus, we must extend the notion of ecological justice beyond a human-centered model to consider the politics of soil labor as a collective activity between systems, communities, and species. By doing so, we can begin to shift the dominant perspective from solution-oriented to establishing fluid, mutualistic systems.
17 Leila Darwish, Earth Repair: A Grassroots Guide to Healing Toxic and Damaged Landscapes (New Society Publishers, 2013)
70 FRUITING BODIES KEY PROJECTS
Mycoremediation is an affordable and interspecies approach to repairing soil damage for human-based activities and the health of soil biota. In 1997, fungi expert Paul Stamets worked with the Washington Transportation Authority to use oyster mushrooms to clean up an oil spill on an adjacent plot of land.18 Within 8 weeks, oyster mushrooms were fruiting on the contaminated soil patch, the soil color drastically changed from a yellow tone to a healthier brown tone, and the lead levels decreased dramatically. Similar to the work of Paul Stamets, the Amazon Mycorenewal Project is an organization that sought to use mycoremediation to remediate oil spills in the Ecuadorian Amazon. The project has extended into other parts of the world where environmental pollution is disproportionately affecting economically and racially marginalized communities.19
Nevertheless, using fungal species to remediate ecological damages is still a technology in its nascent stages. Experts such as Leila Darwish and Peter McCoy point out some of the main barriers to community-based mycoremediation 20 :
1. Microclimates and location specificity require effective mycoremediation applications to be tailored to sitespecific characteristics and conditions, making it challenging to have “readyto-go” stock on hand.
2. There is a lack of social and government funding.

3. Accessible and legible information—current protocols for soil analysis are in scientific jargon, requiring very specific expert knowledge.
IoM attempts to address these pain points found in current mycoremediation systems, in order to imagine what the infrastructure for a feasible, community-based system would look like.

18 Paul Stamets, Mycelium Running: How Mushrooms Can Help Save the World (Crown Publishing Group, 2005)
19 https://www.amazonmycorenewal.org
20 Peter McCoy, Radical Mycology: A Treatise on Seeing & Working with Fungi (Chthaeus Press, 2016)
61 Franklin Street Community Garden,Brooklyn, NY Image credit: New York Times
71 FRUITING BODIES KEY PROJECTS
La Finca del Sur Community Garden, The Bronx, NY Image credit: United Nations
Pleurotis ostreatus (oyster mushrooms) grown on an oil spill

Image credit: Paul Stamets, Mycelium Running
SOIL BIOTA
Diagram of soil-based organisms.
Image credit: Utah Agriculture in the Classroom

72 FRUITING BODIES KEY PROJECTS
How IoM Works
IoM’s main product is a mycoremediation kit, with spores from a lab-engineered mushroom strain specific to localized soil samples. In addition to the kit, the company provides detailed soil testing reports (pre and post remediation), aftercare services, and knowledge-sharing platforms.

After the soil is paired with a mushroom strain, IoM will send the user a set of customized mushroom spores in a syringe kit, a detailed report of the soil
health in a vernacular format based on the principles of ecological succession, and instructions on how to begin the DIY mycoremediation process. The platform also has a Myco Journal App, allowing the user to upload photos of the growth process and soil change every few days, as a way to record the process and also to get feedback and input from IoM’s mycoremediation experts. Finally, IoM has a digital Soil Lab that contains geo-located information about soil health in nearby areas and offers recommendations for postmycoremediation care.
IoM website homepage 73 FRUITING BODIES KEY PROJECTS
Soil Testing and Custom Mycoremediation Kit

The overall process, from soil testing to mycoremediation, is 12-14 weeks. The user sends soil samples to IoM, which will be tested for toxicity levels, nutrition status, and soil biota compounds. The lab will then test the remediation process with different mushroom strains to develop the optimal strain(s). The kit comes in a syringe and capsule system for life-maintenance of the spores. Additionally, to reduce waste footprint, the syringe top is reusable, as well as intuitive and ergonomic to use, with a double-ejection system.

 Sketch of IoM syringe-capsule refill system, in collaboration with Weston Rivell
Sketch of IoM syringe-capsule refill system, in collaboration with Weston Rivell
74 FRUITING BODIES KEY PROJECTS
Renderings of IoM Kit
Prototyping syringe ergonomics

Working with soil.
Image credit: United Nations
 Renderings of IoM syringe-capsule system
Renderings of IoM syringe-capsule system
75 FRUITING BODIES KEY PROJECTS


IoM’s services empower communities to directly respond and reclaim environmental resilience. The mycoremediation process, which takes about 6-8 weeks, should be regularly monitored. Thus, progress rests on the user’s regular maintenance, embedding the principle of invested care in the process. In consideration of this, IoM has the Myco Journal App, a centralized note-taking and information-sharing platform to allow users to best provide this invested care. Users are encouraged to make entries every 2-3 days by uploading photos and filling a series of key observation points: fruiting activity, soil texture, soil-based organisms, etc. They can share their journal entries with the IoM community at large.

Myco Journal App
Journal
78 FRUITING BODIES KEY PROJECTS
Mockup of Myco
App
User research notes for prototyping Myco Journal App flow

79 FRUITING BODIES KEY PROJECTS


80 FRUITING BODIES KEY PROJECTS


81 FRUITING BODIES KEY PROJECTS
Soil Lab
Individual journal entries and observations can be shared through the app and will also appear on IoM’s website in the Soil Lab section. Soil Lab is a knowledge-sharing platform that contains articles and Q&A forums, as well as a growing database of soil information at different geotagged locations from testing records. In aggregating and publishing this soil information, from pollutant levels to recommendations for local companion plants, IoM intends to encourage users to simultaneously contribute to and learn from other users.

Myco Journal App Soil Lab webpage 82 FRUITING BODIES KEY PROJECTS
User Journey
James and Chantel are community garden managers at the 138th Street Community Garden. A recent report from Brooklyn College Soil Research Lab shows that the area where the community garden is situated has high lead levels in the soil. In response to this discovery, James and Chantel are in search of a budget-friendly solution that does not compromise the overall soil microbiome.

1. Gather soil samples, place them in envelopes with correct labeling,and send them to IoM’s lab.
2. Receive a custom mycoremediation kit in 2 weeks with soil test results, DIY instructions, and links to reference videos on IoM’s website.
3. Perform mycoremediation (8 weeks).
4. Use the Myco Journal App to record observations every 1-3 days and communicate any questions to IoM experts and the community.
5. Send new soil samples back after the 8-week mycoremediation process for second-round testing.
6. Receive new results and aftercare instructions.
83 FRUITING BODIES KEY PROJECTS
Image credit: New York Times
User Testing
The initial design phase of this project was largely informed by semistructured interviews conducted with potential users (community garden managers and new homesteaders) and insights around mushroom-growing education derived from workshops I held throughout the thesis process and from my time volunteering at the community bio-lab, Genspace. Through these interviews and desk research, I considered the user behaviors and needs based on experience levels and soil needs.
After the initial designs of IoM’s products and services, I wanted to prototype the key concepts in real life. I delivered mushroom spores to eight participants and held a Zoom workshop where we prepared to grow reishi mushrooms from food and a gricultural waste. After the workshop, I started a Slack channel for the participants to share their observations every few days with any questions. The goal of this prototyping process was to better understand how I can design for community-based mycoremediation endeavors and user behaviors on digital knowledge-sharing platforms. Within a few days of the Slack channel’s inception, people began commenting on each other’s posts with questions, tips, and tricks.
Next Steps: Integrating User and Expert Feedback
During the design process, I consulted several experts, including mycologist Sue Van Hook, former science teacher Jeremy Bergstein, and Mold Magazine editor LinYee Yuan. Through these consultations, I received insightful technical and conceptual feedback on how to evolve and continue this project, in addition to the user f eedback I received from interviews and the workshop session. The experts i ndicated that one way to actualize this project is to partner with local universities and labs to invest in research and testing platforms for a growing database for the community to access.
Additionally, while I was conducting user research, I received interest from small-scale urban agriculture and homestead communities on testing IoM’s mycoremediation model. In this way, there is a lot of promise to design feasible methodologies for mycoremediation that would allow for wider access and evolution than its current state. In order to do so, I am interested in conducting more community-based mushroom-growing workshops to refine the pedagogical and information-sharing process, to test and keep records of different mushroom strains on different soil types, and to work with a community garden as an initial test site. Amidst all of this second
84 FRUITING BODIES KEY PROJECTS
phase prototyping, I think it is critical that I further develop the interspecies component of this project. Currently, the Myco Journal App is the platform where I sought to embed principles of extended stakeholdership and multispecies care. However, to truly

further the politics of this conversation around symbiotic systems and collective interspecies soil labor, the design framework needs to be further explored and concretized.

85 FRUITING BODIES KEY PROJECTS
Screenshots from mushroom knowledge-sharing Slack channel I made after the Zoom workshop I hosted
A Ritual for Growing Mycelium with Food Waste
Rendering: A Last Supper exhibition space

Area of Inquiry
How can we design a ritual of growing mushrooms from food waste as a new mode of material production to instigate relational innovation around interspecies relationships?
Terms
Relational innovation: new perspectives that interrogate and subvert existing relationship frameworks between interconnected entities.
Project Type
Experience and exhibition design
3. A LAST SUPPER
86 FRUITING BODIES KEY PROJECTS
Introducing A Last Supper
A Last Supper is an interactive exhibition that invites participants to engage in the process of growing mycelium vessels with their own recipes of food waste in a ritual format akin to ancestral offering ceremonies in China (供品 gong pin). Through the experience, participants are encouraged to reflect on how things we consider to be at the end of their life can serve as a source for the growth of other life. Can these new relationships change our perspectives about our role within the planetary ecosystem?
The experience incorporates the fundamental aspects of a Chinese ancestral offering ceremony and can be broken down into the following cues:

87 FRUITING BODIES KEY PROJECTS
“That, I think, is the power of ceremony: it marries the mundane to the sacred. The water turns to wine, the coffee to a prayer. The materials and the spiritual middle like grounds mingled with humus, transformed like steam rising from a mug into the morning mist.”
— Robin Wall Kimmerer, Braiding Sweetgrass
Participant Journey
These ritual structures are integrated into the participant journey in the following manner:
1. The participant enters the exhibition space and washes their hands at the hand-washing podium.
2. They read the exhibition text and look at the research wall and material samples.
3. They walk towards the offering table and are greeted by an attendant introducing what the table is.
4. They are interested in participating in the offering ritual, they put on a Tyvek robe, and they find a prep station.
5. They read the ritual guidelines and begin the process by sterilizing the prep area first.
6. They go through the entire prep and embalming process, place the growing vessel on a shelf on the shrine, and fill out a memorial card.
7. They come back a week later to pick up their vessel after the mycelium has grown a substantial amount.
Each memorial card has a quote that evokes emotional reflection around the collaborative relationship between humans and fungi.

88 FRUITING BODIES KEY PROJECTS

 Table for preparing offerings and adding to mushroom spores to grow mycelium vessels
Table for preparing offerings and adding to mushroom spores to grow mycelium vessels
89 FRUITING BODIES KEY PROJECTS
Exhibition text and Research Wall




On Experience Design as Provocation
Mycelium is fascinating because it is an organism that grows life through decomposing other matter. In placing mycelium as the focal point of an offering ceremony meant for the deceased, the experience aims to look at the circularity of life and death through decomposition andrecomposition. The goal of this experience is to provide a relational innovation that sparks empathy and care within the participants in their relationship to waste, consumption, and interspecies collaborative survival.
According to art historian Caroline Jones, an effective approach
Caroline Jones, et al., editors, Experience: Culture Cognition and the Common Sense (The MIT Press, 2016) 41
Orientation
Engagement Conclusion
“to experience design is creating disorienting environments that aim to shift the human umwelt, sensitizing us to the cosmos, modeling experience as the collaboration of common sense.” 21 In the context of A Last Supper, the role of ritual in the experience design is to provide education. It also aims to prompt participants to consider a paradigm shift in object-commodity conditions of production and consumption, through experiencing empathy and connectedness with materials and their living producers. I applied John Dewey’s structure of experience to script the participant interactions into three phases:
Establishing the hand-washing podium as the gate of transformation to indicate to the participant that they are entering into another world (an offering ceremony).
The overall exhibition experience, emphasizing the participation in the mycelium-growing ritual.
The intended shift in mindset after the participant goes through the ritual process.
21
94 FRUITING BODIES KEY PROJECTS
Physical Prototyping
To prototype the concept for A Last Supper, I experimented with growing mycelium with a variety of agricultural and food waste. To grow the mycelium,I placed myself in the mindset of the participant in order to iterate the “feeding” process that would inform the ritual experience.

On Materiality: Digital and Physical Manifestations
Amid COVID, I redesigned the interactive exhibition from a temporary physical space into two alternative manifestations: a kit for a
remote ritual experience and an interactive exhibition set in VR. The remote ritual kit became integrated into the prototyping tools for IoM’s mushroom-growing workshop, as a means to explore the user experience of hands-on making and co-creation. At the same time, I placed the experience into a fully digital space, to emphasize that this thesis is not just about the literal growing of mushrooms, but is also an exploration of materiality and interspecies ecosystems through tangible, functional, and emotional activations.
95 FRUITING BODIES KEY PROJECTS
Experience design prototyping process


A Last Supper ritual kit
96 FRUITING BODIES KEY PROJECTS
Excerpt from A Last Supper VR experience
CONCLUDING THOUGHTS

Conclusion
Spending the past year working at the intersection of biology has been an incredibly eye-opening, existential, challenging, and enjoyable experience. I began the thesis process in the first semester with the intent to experiment and engage in hands-on making as much as possible. I was able to develop a strong technical backbone and a materials-oriented practice from these experiments, but felt lost when deciding on specific applications from these discoveries and learnings. It was very helpful to continue to refine my area of inquiry with subject matter experts and the educational resources provided by Genspace. Digging deeper into the conceptual frameworks that would shape the design of my later work, I’ve come to learn the importance of uncovering and distilling the epistemological and ontological foundations that shape the current state of industrial production. Design is inevitably a product of ideology and sociocultural forces; therefore, as designers, it is critical that we interrogate why and how systems came into being (their inputs, outputs, and feedback loops) in order to create paradigm shifts for new futures. Thus, the next step for continuing this practice and inquiry is to consider avenues where my explorations can materialize.
The demand for ecological justice and a multispecies perspective is more critical than ever as the effects of COVID-19, thus far, have simultaneously revealed to us the fluidity and interconnectedness of our biological identities and the damaging material manifestations brought about by the socioeconomic oppression of capitalist and colonial systems. Echoing the manifesto I presented in this book, I want to emphasize that a multispecies future is tied to embracing and harnessing ancestral practices of land-use and land-care. In Taiwanese and Chinese culture, there is a popular saying, jie di qi (接地气), which translates to “connecting to the land with your physical body to uncover your ancestral energy.” This phrase emphasizes the interconnectedness of lived human experiences, ecology, and the land.
98 FRUITING BODIES CONCLUDING THOUGHTS
“Communities relying on and entangled with fisherman, landless farmers, indigenous communities, or other species, gesture towards creating the conditions for a different understanding of the ecological sphere.”
—Susan Winterling, “The Social Imaginary of Microorganisms”
In an effort to continue this thesis, I have evolved aspects of IoM and my materials practice with mycelium into collaborating with urban agriculture communities, looking at how mycoremediation can become an integral part of subsistence agriculture and land-care. In addition to this, I’ve started a project with a friend and fellow designer, called Superorganic, where we are using design to develop educational material around ecological practices in urban spaces. Through this work, I’m interested in harnessing the principles of involution to reevaluate the humannature dichotomy central to current practices of world-making. I decided to focus on the relationship between materiality and ecology because I believe that in recognizing “the capacity of things—edibles, commodities, stores, metal—not only
to impede or block the will and design of humans but also to act as quasi agents or forces with trajectories, propensities, or tendencies of their own.” 22 The acknowledgement that we live in interspecies ecosystems where labor and materialization are activities defined by relationality and collaboration will allow us to rescript a universal posthuman figure that dismantles exclusive notions of hierarchy and individualism, towards the establishment of mutualistic systems.
I’d like to conclude this book with a quote that has been my north star throughout this thesis process:
22 Jane Bennett, Vibrant Matter: A Political Ecology of Things (Duke University Press, 2009) ii
99 FRUITING BODIES CONCLUDING THOUGHTS
“The task is to make kin in lines of inventive communication as a practice of learning to live and die will with each other in the thick present... to make trouble, to stir up potent responses to devastating events, as well as to settle troubled waters and rebuild quiet places.”
—Donna Haraway, Staying with the Trouble

REFERENCES
Allen, Aaron S. “Sustainability and Sound: Ecomusicology Inside and Outside the Academy.” Music and Politics, vol.8, no.2, Summer 2014. http://www.doi.org/10.3998/ mp.9460447.0008.205. Accessed 10 March 2020.
Armstrong, Chelsey G. and James R. Veteto. “Historical Ecology and Ethnobiology: Applied Research for Environmental Conservation and Social Justice.” Ethnobiology Letters, vol. 6, no. 1, 2015, pp. 5-7. http://doi.org/10.14237/ebl.6.1.2015.313.
Accessed 10 February 2020.
Bailey, Spencer and Andrew Zuckerman. “Neri Oxman on Her Extraordinary Visions for the “Biological Age.” Time Sensitive Podcast. 4 Sept. 2019. https://timesensitive.fm/episode/neri -oxman-extraordinary-visions-biological-age/.
Accessed 27 December 2020.
Bailey, Spencer and Andrew Zuckerman. “Li Edelkoort on Why Doing Less is More.” Time Sensitive Podcast. 4 Dec. 2019. https://timesensitive.fm/episode/trend-forecaster-li-edelkoortdoing-less-is-more/. Accessed 20 December 2020.
Bakari, Mohamed El-Kamel. “Sustainability and Contemporary Man-Nature Divide Aspects of Conflict, Alienation, and Beyond.” Consilience, no. 13, 2015, pp. 195-215. http://www.jstor.org/stable/26427279.
Accessed 10 February 2020.
Barad, Karen. “Posthumanist Performativity: Toward an Understanding of How Matter Comes to Matter.” Material Feminisms, edited by Stacy Alaimo and Susan Hekman. University of Indiana Press, 2008.
Bennett, Jane. Vibrant Matter: A Political Ecology of Things. Duke University Press, 2009.
Braidotti, Rosi. “The Politics of ‘Life Itself’ and New Ways of Dying.” New Materialisms: Ontology, Agency, and Politics, edited by Diana Coole and Samantha Frost. Duke University Press, 2010, pp. 201-218.
Brownell, Blaine, editor. Transmaterial Next: A Catalog of Materials That Redefine Our Future. Princeton Architectural Press, 2017.
Carson Center, 2016, pp. 21-26. https:// www.jstor.org/stable/26241354. Accessed 10 March 2020.
Chieza, Natsai, et al. “Design with Science.” Journal of Design and Science, issue 4, The MIT Press, 2019. http://www.jods.mitpress. mit.edu/pub/issue4-agapakis-lee. Accessed 10 January 2020.
Darwish, Leila. Earth Repair: A Grassroots Guide to Healing Toxic and Damaged Landscapes. New Society Publishers, 2013.
Dean, Jodi. “The Anamorphic Politics of Climate Change.” e-flux Journal, no. 60, January 2016. https://www.e-flux.com/journal/69/60586/ the-anamorphic-politics-of-climate-change/. Accessed 20 February 2020.
Dorr, Alex. Mycoremediation Handbook: A Grassroots Guide to Cleaning up Toxic Wastes with Fungi. Self-published, 2018.
Dumitriu, Anna and Blay Whitby. “Cybernetic Bacteria.” Leonardo, vol. 44, no. 3, The MIT Press, 2001, pp. 264-265. https://www. jstor.org/stable/20869466. Accessed 10 March 2020.
Franklin, Kate and Caroline Till. Radical Matter: Rethinking Materials for a Sustainable Future. Thames and Hudson, 2018.
102 FRUITING BODIES REFERENCES
Garibay-Orijel, Roberto, et al. “Women Care About Local Knowledge, Experiences from Ethnomycology.” Journal of Ethnobiology and Ethnomedicine, 8:25, 2012. http://www.ethnobiomed.com/content/8/1/25.
Accessed 9 February 2020.
“Get to Know Your Soil.” Seattle Public Utilities. 8 June 2001. http://www.savingwater.org/ wp-content/uploads/Get-to-know-your-soil.pdf.
Accessed 15 April 2020.
Gilbert, Scott F., et al. “A Symbiotic View of Life: We Have Never Been Individuals.” The Quarterly Review of Biology, vol 84, no. 4, 2012, pp. 325-341. https://www.jstor.org/stable/ 10.1086/668166. Accessed 2 April 2020.
Ginsberg, Alexandra D, et al. “Decentralizing Biotech.” Journal of Design and Science, issue 4, The MIT Press, 2019. http://www. jods.mitpress.mit.edu/pub/issue4-okafor-ajioka.
Accessed 10 January 2020.
Ginsberg, Alexandra D. and Natsai Chieza. “Editorial: Other Biological Futures.” Journal of Design and Science, issue 4, The MIT Press, 2019. http://www.doi.org/ 10.21428/566868b5. Accessed 20 October 2020.
Ginsberg, Alexandra D, et al. “Future Shaped by Pasts that Could Have Been.” Journal of Design and Science, issue 4, The MIT Press, 2019. http://www.doi.org/10.21428/5e41a54a. Accessed 10 January 2020.
Ginsberg, Alexandra D, et al. “Thinking Edibility Otherwise.” Journal of Design and Science, issue 4, The MIT Press, 2019. http://www. jods.mitpress.mit.edu/pub/issue4-evansgovera. Accessed 10 January 2020.
Ginsberg, Alexandra D., et al. Synthetic Aesthetics: Investigating Synthetic Biology’s Designs on Nature. The MIT Press, 2014.
Haraway, Donna. Staying with the Trouble: Making Kin in the Chthulucene. Duke University Press, 2016.
Haraway, Donna. “Tentacular Thinking: Anthropocene, Capitalocene, Chthulucene.” e-flux Journal, no. 75, 2016. http://www.e-flux.com/ journal/75/67125/tentacular-thinking-anthropocene-capitalocene-chthulucene/. Accessed 19 December 2019.
Haraway, Donna and Drew Endy. “Tools for Multispecies Futures.” Journal of Design and Science, issue 4, The MIT Press, 2019. http://www. doi.org/10.21428/7808da6b.05eca6f1. Accessed 10 January 2020.
Harman, Graham. Object-Oriented Ontology: A New Theory of Everything. Pelican Books, 2018.
Jain, Abhinav, et al. “Fungal-Mediated Solid Waste Management: A Review.” Mycoremediation and Environmental Sustainability, vol. 1, 2017, 152-182. http://www.doi. org/19.1007/978-3-319-68957-9_8.
Accessed 14 February 2020.
Jiang, Lan. “The Return of Gaia.” Leap Magazine, issue 44, pp. 90-99.
Kimmerer, Robin W. Braiding Sweetgrass: Indigenous Wisdom, Scientific Knowledge, and the Teachings of Plants. Milkweed Editions, 2013.
Kulshreshtha, Shweta. “Mushroom as a Product and Their Role in Mycoremediation.” AMB Express, 4:29, 2014. http://www.amb-express.com/ content/4/1/29. Accessed 14 February 2020.
Krzywoszynska, Anna. “Nonhuman Labor and the Making of Resources: Making Soils a Resource through Microbial Labor.” Environmental Humanities, vol 12, issue 1, May 2020, 227-249. https://doi.org/10.1215/22011919-8142319.
Accessed 15 May 2020.
103 FRUITING BODIES REFERENCES
Latour, Bruno. Down to Earth: Politics in the New Climate Regime. Polity, 2018.
Latour, Bruno. We Have Never Been Modern. Translated by Catherine Porter, Harvard University Press, 1993.
Liboiron, Max. “Redefining Pollution and Action: The Matter of Plastics.” Journal of Material Culture, vol 21, issue 1, December 2015, pp. 87-110. https://doi.org/ 10.1177/1359183515622966. Accessed 15 December 2020.
Lipps, Andrea, et al. Nature: Collaborations in Design. Cooper Hewitt, Smithsonian Design Museum, 2019.
Margulis, Lynn. Symbiotic Planet: A New Look at Evolution. Basic Books, 2008.
McCoy, Peter. Radical Mycology: A Treatise on Seeing & Working with Fungi Chthaeus Press, 2016.
Mishra, Rashmi and V. Venkateswara Sarma. “Mycoremediation of Heavy Metal and Hydrocarbon Pollutants by Endophytic Fungi.” Mycoremediation and Environmental Sustainability, vol. 1, 2017, pp. 132-152. www.doi. org/19.1007/978-3-319-68957-9_8. Accessed 14 February 2020.
Morton, Timothy. Dark Ecology: For a Logic of Co-existence. Columbia University Press, 2016.
Morton, Timothy. Hyperobjects: Philosophy and Ecology After the End of the World. University of Minnesota Press, 2013.
Morton, Timothy. Ecology Without Nature University of Minnesota Press, 2013.
Myers, William. Bio Design: Nature, Science, Creativity. Thames and Hudson, 2012.
Paltseva, Anna and Zhongqi Cheng. “Application of GIS to Characterize Garden Soil Contamination in New York City.” Global Symposium on Soil Pollution, 2018.
Pellerin, Emily R. “Lickable Cities.” Mold: The Future of Food, issue 4, 2019, pp. 152-155.
Penty, Jane. Product Design and Sustainability: Strategies, Tools and Practice. Routledge, 2019.
Plank, Owen. Soil Testing: For Home Lawns, Gardens and Wildlife Food Plots. University of Georgia Cooperative Extension, 2015. https://secure.caes.uga.edu/extension/ publications/files/pdf/C%20896_5.PDF.
Accessed 5 April 2020.
“Polluting Our Soils is Polluting Our Future.” Food and Agriculture Organization of the United Nations. 5 Feb. 2018, http://www.fao.org/ fao-stories/article/en/c/1126974/.
Accessed 8 April 2020.
Pombo, Maria Elena. Personal Interview. 13 April 2020.
Rao, Tejal. “Food Supply Anxiety Brings Back Victory Gardens.” The New York Times. 25 March 2020. https://www.nytimes. com/2020/03/25/dining/victory-gardens-coronavirus.html. Accessed 10 April 2020.
Sanderson, Eric W. Mannahatta: A Natural History of New York City. Abrams, 2009.
Schine, Jennifer. “Soundwalking: Ways of Listening to the Biological World.” International Society of Ethnobiology, 2012. http://www.ethnobiology.net/schine-2012congress/. Accessed 5 March 2020.
Schlanger, Zöe. “Our Microbes, Ourselves.” Method Quarterly. http://www. methodquarterly.com/2015/11/our-microbes-ourselves/. Accessed 10 May 2020.
104 FRUITING BODIES REFERENCES
Sheldrake, Merlin. Entangled Life: How Fungi Make Our Worlds, Change Our Minds, and Shape Our Futures. Random House, 2020.
Sheri, Yasaman. “Sensing Manifesto.” Mold: The Future of Food, issue 4, 2019, pp. 4-9.
Solanki, Seetal. Why Materials Matter. Prestel, 2018.
“SPACE10 Session: Designing for Dignity and Practices of Care.” http://vimeo. com/42765017. Accessed 9 June 2020.
Stairs, David. “Biophilia and Technolophilia: Examining the Nature/Culture Split in Design Theory.” Design Issues, vol. 13, no. 3, The MIT Press, 1997, pp. 37-44. http://www.jstor.org/stable/1511939. Accessed 10 March 2020.
Stamets, Paul. Mycelium Running: How Mushrooms Can Help Save the World. Crown Publishing Group, 2005.
Sullivan, Charlotte. Personal Interview. 10 October 2019.
TallBear, Kim. “Why Interspecies Thinking Needs Indigenous Standpoints.” Fieldsights, 18 November 2011. https://culanth.org/fieldsights/ why-interspecies-thinking-needsindigenous-standpoints. Accessed 30 January 2020.
Thomas, AnnMarie and Mark Breitenbeg. “Engineering for Non-engineers: Learning from ‘Nature’s Designs’.” American Society for Engineering Education, 2007.
Tsing, Anna L. The Mushroom at the End of the World: On the Possibility of Life in Capitalist Ruins. Princeton, Princeton University Press, 2015.
Jones, Caroline, et al., editors. Experience: Culture Cognition and the Common Sense. The MIT Press, 2016.
Umansky, Valentine. “Finding a Common Roof: Artists as Ecologists.” Leap Magazine, issue 44, pp.157-165.
Van Hook, Sue. Personal Interview. 2 October 2019.
Welch, James, et al. “Historical Ecology and Ethnobiology: Applied Research for Environmental Conservation and Social Justice.” Ethnobiology Letters, vol. 6, no. 1, 2015, pp. 106. https://doi.org/10.14237/ebl.6.1.2015.313. Accessed 8 February 2020.
Winterling, Susan. “The Social Imaginary of Microorganisms.” Sonic Acts: Hereafter. Sonic Arts Press, 2019, pp. 72-79.
Wright, Claire. “Towards an Interdisciplinary Focus on Sound in Ethnobiology Research.” Ethnobiology Letters, vol. 8, no.1, 2017, pp. 58-60. www.jstor.org/stable/26423676. Accessed 10 February 2020.
Yarmuth, Lauren. “Closing the Loop.” Mold: The Future of Food, issue 3, 2018, pp. 5-10.
Youatt, Rafi. “Anthropocentrism and the Politics of the Living.” Reflections on the Posthuman in International Relations. Bristol, E-International Relations, 2017.
Youatt, Rafi. Counting Species: Biodiversity in Global Environmental Politics University of Minnesota, 2015.
Youatt, Rafi. “Interspecies.” The Oxford Handbook of Environmental Political Theory. Oxford University Press, 2016.
Yuan, LinYee. Personal Interview. 10 April 2020.
Yuhui, Jiang. “Beauty is the Beginning of Terror: The Philosophy of Disaster and PostApocalyptic Art.” Leap Magazine, issue 44, pp. 100-111.
105 FRUITING BODIES REFERENCES
Biomaterials Experimentation: agar bioplastic

 Working with Fungi: Pleurotis ostreatus grown on an agar plate
Working with Fungi: Pleurotis ostreatus grown on an agar plate
Acknowledgment
A tremendous and heartfelt thank you to the SVA faculty and staff for their guidance throughout this process. I am also immensely grateful to my friends and mentors for your support as I did quite a few mental gymnastics around this topic. Lastly, a special thanks to Harvard Herbaria and Genspace for the amazing research resources.

 By Helen Yin Chen
By Helen Yin Chen






 Birkenwerder, Brandenburg, Germany, October 2016
Birkenwerder, Brandenburg, Germany, October 2016










 Mushroom entrepreneurs in Zimbabwe Image credit: Future of Hope Foundation
Mushroom entrepreneurs in Zimbabwe Image credit: Future of Hope Foundation



 11 Anna, Krzywoszynska “Nonhuman Labor and the Making of Resources: Making Soils a Resource through Microbial Labor,” Environmental Humanities (vol 12, issue 1, May 2020) 236.
12 Rafi Youatt, “Anthropocentrism and the Politics of the Living,” Reflections on the Posthuman in International Relations (Bristol, E-International Relations, 2017) 40.
Interspecies communication app Image credit: The Living
11 Anna, Krzywoszynska “Nonhuman Labor and the Making of Resources: Making Soils a Resource through Microbial Labor,” Environmental Humanities (vol 12, issue 1, May 2020) 236.
12 Rafi Youatt, “Anthropocentrism and the Politics of the Living,” Reflections on the Posthuman in International Relations (Bristol, E-International Relations, 2017) 40.
Interspecies communication app Image credit: The Living

 Microbial Home Diagram Image credit: Cedric Bernard
Microbial Home Diagram Image credit: Cedric Bernard

Processing DNA cells from saliva sample Biohacking Bootcamp, Genspace Fall 2019
DNA sequence in agarose under UV light Biohacking Bootcamp, Genspace Fall 2019
Processing DNA cells from saliva sample Biohacking Bootcamp, Genspace Fall 2019
DNA sequence in agarose under UV light Biohacking Bootcamp, Genspace Fall 2019

Preparing to grow pleurotis ostreatus (osyter mushroom) in a coffee husk, grains, and plastic bag substrate
Preparing to grow pleurotis ostreatus (osyter mushroom) in a coffee husk, grains, and plastic bag substrate







 Turkeytail mushroom gills examined under a microscope
Plastic bag pieces and grain substrate for growing oyster mushrooms
Turkeytail mushroom gills examined under a microscope
Plastic bag pieces and grain substrate for growing oyster mushrooms





 Photo excerpts from co-creation workshop highlighting the different aspects of the three-part workshop
and filling out the Sensing Worksheet
Photo excerpts from co-creation workshop highlighting the different aspects of the three-part workshop
and filling out the Sensing Worksheet









 Participants brainstorming with Biomimic-Me! cards
Participants brainstorming with Biomimic-Me! cards

 Physical protoype of Biomimic-Me! cards used in the workshop
Physical protoype of Biomimic-Me! cards used in the workshop













 Sketch of IoM syringe-capsule refill system, in collaboration with Weston Rivell
Sketch of IoM syringe-capsule refill system, in collaboration with Weston Rivell

 Renderings of IoM syringe-capsule system
Renderings of IoM syringe-capsule system
















 Table for preparing offerings and adding to mushroom spores to grow mycelium vessels
Table for preparing offerings and adding to mushroom spores to grow mycelium vessels










 Working with Fungi: Pleurotis ostreatus grown on an agar plate
Working with Fungi: Pleurotis ostreatus grown on an agar plate
